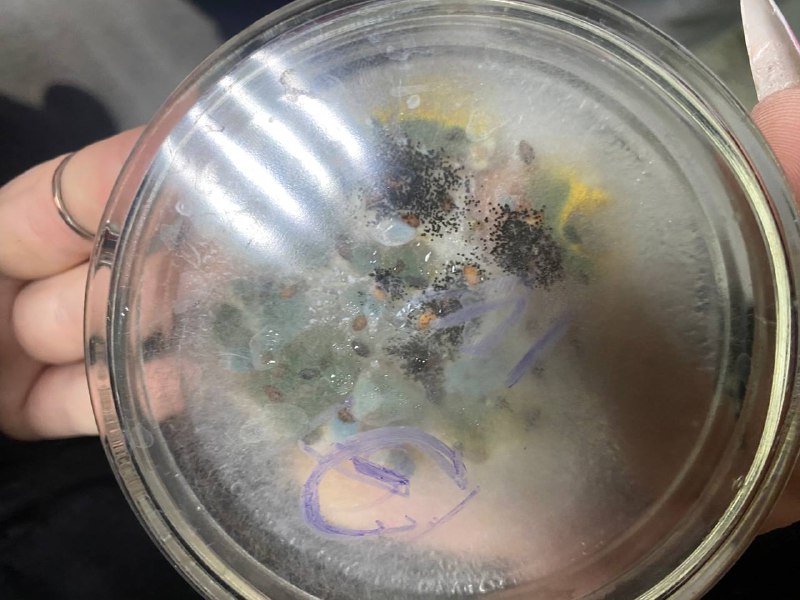

- Расписание звонков
- Расписание занятий, замены
- Кружки, секции
- Спортивный клуб "Факел"
- Приглашаем к участию
- Студенческое самоуправление
- Студенческие общежития
- Заочнику
- Производствено-практическое обучение
- Вакантные места
- Служба маркетинга
- Национальная система квалификаций
- Классные руководители
- Полезная информация
- Книга рекордов колледжа
- Газета "Студенческий формат"
- Библиотека